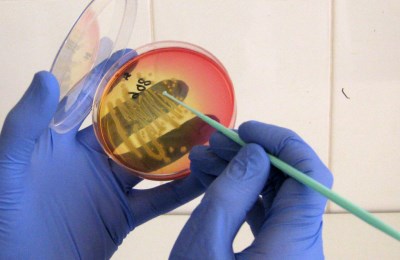

Что такое фарингит? Фарингит – это воспалительного характера поражение слизистой оболочки, а также лимфоидных тканей гортани.
Заболевание может как развиваться само по себе, и быть самостоятельной болезнью, так и быть последствием другого патологического процесса, часто встречается как у взрослых, так и у детей.
Возможные причины развития
К возможным причинам развития фарингита следует причислять как контакт с различными инфекционными возбудителями, так и регулярное и длительное пребывание в неблагоприятных условиях окружающей среды.
К факторам окружающей среды, способным в зависимости от продолжительности и интенсивности воздействия вызвать острый или хронический фарингит:
Высокая температура вдыхаемого воздуха.
- Низкая температура вдыхаемого воздуха.
- Наличие большого количества крупных или мелких частичек пыли.
- Раздражающие, или химически агрессивные вещества.
- Длительное пребывание в условиях задымленности.
Также стать причиной, вследствие воздействия которой разовьется острый, а при отсутствии адекватного лечения хронический фарингит, может достаточно большое количество как инфекционных агентов как бактериальной, так и вирусной природы.
Фарингит представляет собой воспаление слизистой оболочки глотки, которое может быть вызвано вирусами, бактериями или аллергическими реакциями. Врачи отмечают, что заболевание может проявляться в острой и хронической формах. Острая форма часто сопровождается резкой болью в горле, повышением температуры и общим недомоганием. В большинстве случаев она вызвана вирусной инфекцией и проходит самостоятельно в течение нескольких дней. Хронический фарингит, напротив, может развиваться на фоне постоянного раздражения, например, из-за курения или аллергии, и требует более тщательного лечения. Врачи подчеркивают важность своевременной диагностики и индивидуального подхода к каждому пациенту, так как неправильное лечение может привести к осложнениям.
Виды
Острый фарингит
Развивается достаточно быстро, период времени от воздействия повреждающего фактора или инфекционного агента на слизистую оболочку глотки, до появления симптомов минимален.
Так как наиболее частые возбудители – бактерии и вирусы, то и заболевание передается преимущественно воздушно-капельным путём.
При соответствующем лечении прогноз благоприятный – заболевание проходит без каких-либо негативных последствий, как у взрослых, так и у детей.
Виды острого фарингита:
-
Острый бактериальный.
Острый бактериальный фарингит вызывает целый ряд возбудителей: стафилококки, стрептококки, пневмококки и многие другие.
Характерные симптомы: ощущение першения и дискомфорта в горле, боль при глотании, болезненные шейные и нижнечелюстные лимфоузлы.
Общеинтоксикационные симптомы при этом более характерны для вирусного фарингита.
Фарингоскопия показывает характерные изменения задней стенки глотки и нёбных дужек. Больной заразен для окружающих, заболевание достаточно часто встречается у детей, так как предается воздушно-капельным путём.
-
Острый вирусный.
Для вирусного фарингита кроме боли в горле и боли при глотании также характерны общеинтоксикационные проявления – головная боль, слабость, повышенная утомляемость, сонливость.
Болезнь может сопровождаться болями в животе, диареей, конъюктивитом, насморком или кашлем, что будет говорить в пользу вирусной природы заболевания.
При попытке перенести заболевание «на ногах» фарингит осложняется бактериальным компонентом, а заболевание поражает все больше людей, ведь больной вирусным фарингитом заразен.
Острый фарингит нередко встречается у детей. Предается воздушно-капельным путём.
-
Грибковый.
Вызывается дрожжевыми, реже плесневыми грибами, у пациентов, ослабленных длительными заболеваниями или с иммунодефицитами другой природы, от человека к человеку не передается.
Кроме боли в горле, повышения температуры тела, сухости в горле и проявлений общей интоксикации больных также зачастую беспокоит сухой кашель.
Фарингоскопия показывает наличие белого или серого налёта, иные специфические симптомы отсутствуют. У детей встречается редко, чаще у взрослых.
-
Острый травматический.
Травматический фарингит развивается без участия инфекционных возбудителей, а возникает после механического повреждения тканей гортани. Симптомы в данном случае зависят от объёма и локализации повреждения.
Фарингоскопия в данном случае необходима не только для постановки диагноза, но и для удаления возможного инородного тела (что особенно часто встречается у детей).
-
Аллергический.
Воспаление развивается как следствие реакции гиперчувствительности.
Характерными признаками является боль в гортани, сухость, возможен сухой кашель.
Фарингоскопия определяет наличие отёка гортани при отсутствии признаков бактериального или грибкового поражения.
Симптомы травматизации также отсутствуют.
Также при сборе анамнеза обращают внимание на ранее встречавшиеся у пациента аллергические реакции.
- Некоторые специалисты также выделяют рефлюксный фарингит, который развивается как следствие заброса химически агрессивного желудочного содержимого.
Фарингит — это воспаление слизистой оболочки глотки, которое может быть вызвано вирусами, бактериями или аллергическими реакциями. Люди часто описывают его как неприятное состояние, сопровождающееся болью в горле, сухостью и дискомфортом при глотании. В зависимости от причины, фарингит может протекать в острой или хронической форме. Острая форма, как правило, возникает внезапно и сопровождается выраженными симптомами, такими как высокая температура и общая слабость. Хронический фарингит, напротив, может развиваться постепенно и проявляться лишь легким дискомфортом. Многие отмечают, что при отсутствии должного лечения заболевание может затянуться, вызывая дополнительные осложнения. Важно помнить, что своевременная диагностика и правильное лечение помогут избежать серьезных последствий.
Хронический фарингит
В зависимости от характерных макро и микроскопических изменений в слизистой оболочке хронический фарингит может иметь следующие формы: субатрофический, атрофический, гипертрофический, катаральный.
-
Субатрофический хронический фарингит.
Хронический субатрофический фарингит можно рассматривать как начальную стадию атрофического.
При этом заболевании в слизистой оболочке гортани происходит ряд патологических изменений – она постепенно истончается, уменьшается количество желёз, продуцирующих слизь.
Сама же слизь становится вязкой, а при высыхании образует корочки, при отделении которых происходит травматизация слизистой оболочки.
Фарингоскопия определяет специфический внешний вид слизистой оболочки – она как будто покрыта лаком. Болезнь редко встречается у детей.
-
Атрофический.
Хронический атрофический фарингит сопровождается дальнейшим уменьшением количества желёз, истончением слизистой, а также замещением её соединительной тканью. Количество сосудов и нервных окончаний также постепенно уменьшается, благодаря чему боли почти нет.
Симптомы похожи на субатрофический фарингит. На запущенных стадиях заболевание эффективному лечению не подлежит, так как этиотропной терапии нет. У детей диагностируют не часто.
-
Гипертрофический.
В некоторых случаях длительно воспаление слизистой оболочки глотки приводит к её утолщению.
Хронический гипертрофический фарингит также отличается образованием различных узелков или гранул.
Слизь часто имеет примесь гноя. У детей встречается редко.
-
Катаральный хронический фарингит.
Развивается при переходе вирусного или бактериального фарингита в хроническую форму. Характерно замедление процессов циркуляции крови и лимфы в лимфоидной ткани глотки, что ещё больше ослабляет иммунную защиту, и способствует длительному течению заболевания.
Специфических жалоб, кроме длительного течения, нет. Наблюдается и у взрослых, и у детей, но после 40-45 лет встречается значительно чаще.
Симптоматика разных видов
Условно симптомы фарингита можно разделить на характерные для всех форм заболевания и специфические. Характерными практически для любого фарингита будут боль при глотании, ощущение инородного тела в горле, першение.
Фарингоскопия определяет покраснение стенок глотки, а также нёбных дужек. Для вирусной этиологии заболевания будут характерны симптомы обще интоксикации, а также проявления поражения других органов – к примеру, пищеварительной системы.
Для бактериального фарингита характерно увеличение лимфатических узлов, при меньшей, чем при вирусном фарингите, выраженности интоксикации.
Хронический атрофический и гипертрофический фарингиты отличаются картиной при фарингоскопии, а также наличием при гипертрофической форме жалоб на обильное отделение слизи, зачастую с прожилками гноя.
В некоторых случаях дифференциальная диагностика различных форм фарингитов вызывает существенные затруднения даже у практикующих оториноларингологов, так как симптомы достаточно похожи, поэтому крайне нежелательно заниматься самолечением – без точно установленного диагноза адекватную терапию назначить невозможно.

Диагностика
Постановка диагноза при фарингите основывается на данных анамнеза, лабораторных и инструментальных исследованиях.
Из лабораторных методов значительной точностью отличается бактериологический метод поиска возбудителя, а также серологические реакции и постановка полимеразной цепной реакции.
Бактериологический метод позволяет не только точно установить бактерию, которая вызвала фарингит у конкретного больного, но и выяснить чувствительность возбудителя к антибиотикам. Серологические реакции позволяют идентифицировать не только бактерии, но и вирусы.
Метод полимеразной цепной реакции позволяет выполнять точную идентификацию любого возбудителя, имеющего РНК или ДНК.
Также повсеместно оториноларингологами используется такой метод как фарингоскопия.
Это осмотр гортани при помощи специальных инструментов, или оптико-волоконным устройством. Позволяет визуально оценить состояние слизистой оболочки, благодаря чему зачастую становится возможным не только установить наличие фарингита, но и определить его вид.
Так, при грибковом фарингите обнаруживается жёлтоватый или беловатый налёт, при атрофическом – признаки истончения и склерозирования, при гипертрофическом возможно обнаружение утолщения слизистой оболочки, а также появление разнообразных узелков.
Меры профилактики и способы лечения фарингита
Достаточно эффективными мерами профилактики фарингита являются закаливание, здоровое рациональное питание, соответствующая возрасту физическая активность.
Немаловажен также и приём витаминных и общеукрепляющих препаратов, особенно в зимне-весенний период.
Неплохо поднимает сопротивляемость организма как к вирусным, так и к бактериальным инфекциям такой препарат как Immunity, приём которого эффективен не только для цели предупредить заболевание, но и для лечения, если первые симптомы уже появились.
Лечение фарингитов преимущественно консервативное, хирургические вмешательства выполняют в большинстве случаев по поводу гипертрофического фарингита.
Медикаментозное лечение назначают исходя из природы возбудителя, это могут быть антибиотики, противовирусные препараты или противогрибковые средства.

Вопрос-ответ
Каковы основные симптомы фарингита?
Симптомы фарингита могут включать боль в горле, затрудненное глотание, сухость и раздражение в горле, а также покраснение и отек слизистой оболочки. В некоторых случаях могут наблюдаться общие симптомы, такие как головная боль, повышенная температура и утомляемость.
Какие факторы могут способствовать развитию фарингита?
Фарингит может развиваться из-за различных факторов, включая вирусные и бактериальные инфекции, аллергические реакции, раздражение от курения или загрязненного воздуха, а также переохлаждение. Часто заболевание возникает на фоне простуды или гриппа.
Как лечится фарингит и какие меры профилактики существуют?
Лечение фарингита обычно включает отдых, обильное питье, полоскания горла солевыми растворами и применение обезболивающих средств. В случае бактериальной инфекции могут быть назначены антибиотики. Профилактика включает избегание контакта с инфекционными больными, поддержание иммунной системы и отказ от курения.
Советы
СОВЕТ №1
Обратите внимание на симптомы. Если вы заметили боль в горле, затрудненное глотание или изменение голоса, не игнорируйте эти признаки. Раннее обращение к врачу поможет избежать осложнений и правильно диагностировать заболевание.
СОВЕТ №2
Поддерживайте водный баланс. Употребление достаточного количества жидкости поможет увлажнить горло и снизить дискомфорт. Теплые чаи с медом или лимоном могут оказать успокаивающее действие.
СОВЕТ №3
Избегайте раздражителей. Курение, алкоголь и острые продукты могут усугубить симптомы фарингита. Постарайтесь исключить их из своего рациона на время болезни, чтобы облегчить состояние.
СОВЕТ №4
Следите за гигиеной. Регулярное мытье рук и использование индивидуальных предметов личной гигиены помогут предотвратить распространение инфекции и защитить вас от повторного заражения.

Высокая температура вдыхаемого воздуха.